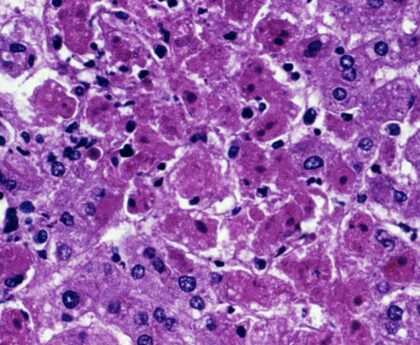

Un nou trend global a apărut pe TikTok, rețeaua socială preferată a tinerilor. Trendul este numit NPC, care înseamnă Non-Playing Character sau, mai precis, personaje care apar într-un joc video, dar nu pot fi controlate de către jucător.
Acest trend a devenit popular nu doar în afara țării noastre, ci și în România. Practic, zeci de mii de tineri, dar și adulți, petrec ore întregi imitând aceste personaje din jocurile video, cu scopul de a obține sume impresionante de bani sub forma unor cadouri virtuale.
@_adr_7.7.7 Mitrică NPC #foryou #foryouromania???????? #npc #mitrica #viral #fypシ #fy ♬ sunet original – ????Adrian????
Un polițist ar fi furat borseta unui bărbat implicat într-un accident rutier. Ce a pățit agentul
De fiecare dată când primesc o sumă de bani sub forma unui cadou virtual, precum un trandafir, aceștia reacționează la comanda utilizatorului. Creatorii de conținut ajung astfel să obțină sume impresionante de bani, dar într-un final se umilesc și atrag comentarii jignitoare din partea internauților.
@pinocchiosuparatu #bahoi #bahoiconstanta #bahoinpc #npcromania #foryou #5pasidebine #foryouromania #viraltiktok #viralromania ♬ original sound – Pinocchio Nbn
În România, oamenii care fac acest câștigă lunar chiar și o mie de euro.
@dianaaaa5675 #npcromania ♬ original sound – ????